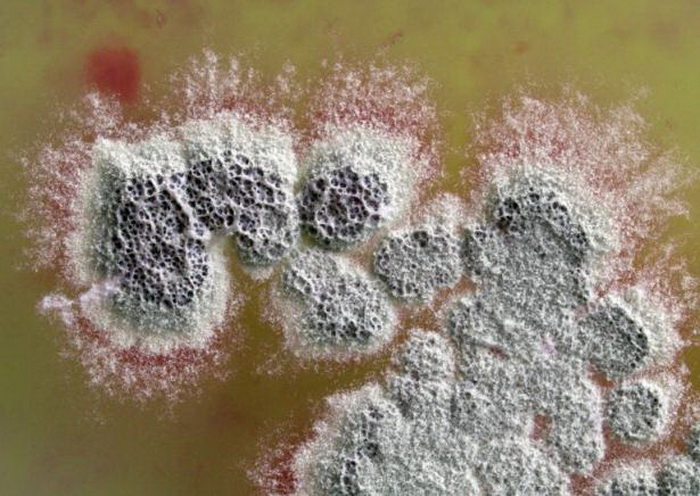

Kháng sinh có thể tiêu diệt siêu vi khuẩn được phát hiện trong vi khuẩn đất
Ngày đăng: 11/11/2025 09:30
Hôm nay: 0
Hôm qua: 0
Trong tuần: 0
Tất cả: 0
Ngày đăng: 11/11/2025 09:30
Hợp chất trung gian premethylenomycin C lactone được phát hiện trong vi khuẩn đất Streptomyces coelicolor có hoạt tính kháng khuẩn mạnh hơn 100 lần so với kháng sinh methylenomycin A.
Một khuẩn lạc vi khuẩn Streptomyces coelicolor tiết ra một hợp chất kháng sinh (màu đỏ) vào môi trường xung quanh. Ảnh: Science Photo Library
Trong quá trình nghiên cứu con đường phân tử mà vi khuẩn đất Streptomyces coelicolor sử dụng để tạo ra kháng sinh methylenomycin A, các nhà khoa học tại ĐH Warwick, Anh, đã phát hiện ra một hợp chất trung gian là premethylenomycin C lactone có hoạt tính kháng khuẩn mạnh hơn 100 lần so với sản phẩm cuối cùng.
Cụ thể, premethylenomycin C lactone hiệu quả hơn nhiều so với methylenomycin A trong nhắm mục tiêu vào bảy chủng vi khuẩn Gram dương, bao gồm Staphylococcus aureus gây nhiễm trùng da, máu và các cơ quan nội tạng, và Enterococcus faecium gây nhiễm trùng máu và tiết niệu.
Nồng độ premethylenomycin C lactone tối thiểu cần để tiêu diệt các chủng Staphylococcus aureus kháng thuốc chỉ là 1 μg/ml, so với 256 μg/ml methylenomycin A. Hợp chất này cũng có thể tiêu diệt vi khuẩn ở liều lượng nhỏ hơn nhiều so với liều lượng vancomycin cần thiết - một loại kháng sinh “dòng cuối” để điều trị nhiễm trùng do hai chủng Enterococcus faecium gây ra.
E. faecium cũng không dễ dàng phát triển khả năng kháng thuốc với premethylenomycin C lactone, khi hiệu quả của hợp chất này không thay đổi sau 28 ngày thí nghiệm. Ngược lại, vi khuẩn được xử lý bằng vancomycin đã đột biến và phát triển khả năng kháng thuốc, và cần liều thuốc cao gấp tám lần để ngăn chặn sự phát triển của chúng.
Đầu năm nay, các tác giả nghiên cứu đã kết hợp với một nhóm khác để phát triển một phương pháp tổng hợp kháng sinh tiết kiệm chi phí bằng cách sử dụng vật liệu thương mại, có thể giúp sản xuất kháng sinh ở quy mô lớn.
Nguồn: nature.com
Tin đăng KH&PT số 1369 (số 45/2025)
Khoahocphattrien